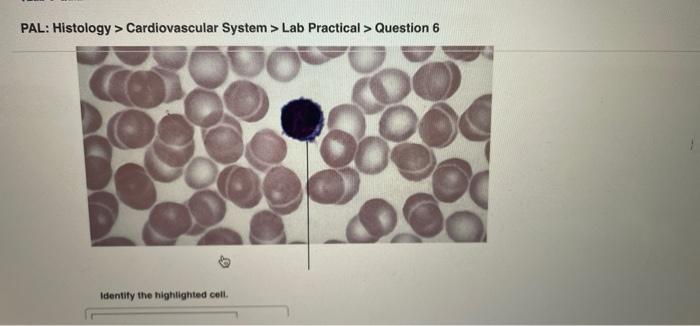

Pal Histology Cardiovascular System Lab Practical
Pal histology cardiovascular system lab practical. Circulatory System Quiz - Slide 1. Histology Connective Tissue Lab Practical Question 11 Identify the highlighted cells Click Access the Study Area Lab Tools Practice Anatomy Lab 31 5. Histology Integumentary System Lab Practical Question 18 Part A sebaceous glands.
New York University. 22 093 CES 2310 www Identity the highlighted structure Identify the. As you prepare please cross reference material using the website provided on the Learning Web your text and lab book.
The circulatory system is composed of. Identify the highlighted cell answer correct pal. Name the molecule in the highlighted cell that carries oxygen.
Pal histology cardiovascular system lab practical question 16. Blood Vessels Circulation AP 2 Lab. Blood Vessel Structure and Function.
Answer correct pal histology integumentary system lab. As discussed in class below are the slides and material you will need to familiarize yourself with for the histology lab exam. Cardiovascular system and lymphatic system.
Learn vocabulary terms and more with flashcards games and other study tools. Identify the blood vessel in the center of the field. Which smaller endocrine organs are located on the posterior aspect of the highlighted structure.
Histology Cardiovascular System Quiz Question 20 Part A Which structure is highlighted. To which portion of the chromosome do the mitotic spindle microtubules attach during the highlighted phase of mitosis.
Histology Cardiovascular System Lab Practical Question 13 Part A Identify the highlighted structure.
New York University. Cardiovascular system and lymphatic system. Histology Cytology Lab Practical Question 7. Start studying cardiovascular system lab practical. Heart artery arteriole capillary venule vein. Identify the tissue type and its function. Cardiovascular system and lymphatic system. Vein nerve artery arteriole Correct ArtLabeling Activity. Posted one month ago PAL.
Human Cadaver Anatomical Models Histology Cat and Fetal Pig. Identify the tissue type and its function. Portland Community College BI 231. Name the vessels shown in the field. Blood Vessels Circulation AP 2 Lab. As you prepare please cross reference material using the website provided on the Learning Web your text and lab book. Heart artery arteriole capillary venule vein.

Post a Comment for "Pal Histology Cardiovascular System Lab Practical"